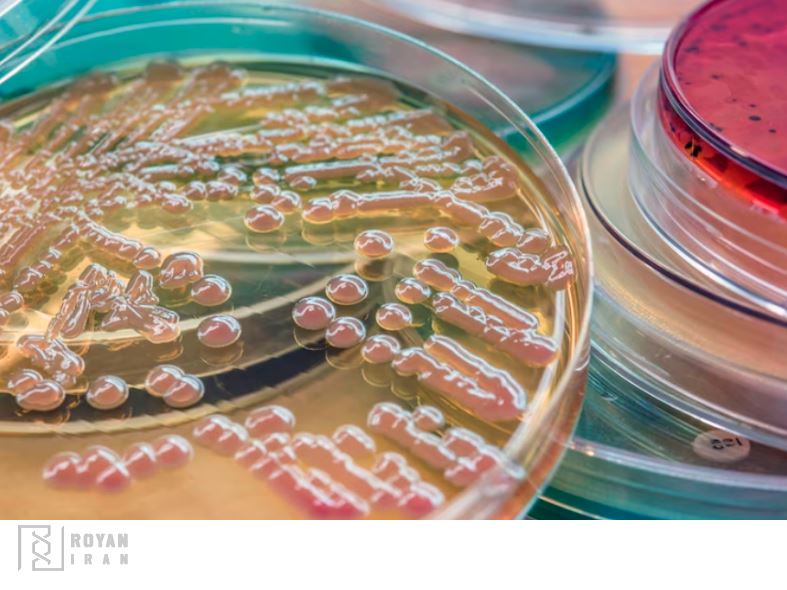
معیارهای انتخای محیط کشت مناسب

رشد میکروارگانیسم در محیط کشت راهی برای مطالعه انواع آن ها
میکروارگانیسم ها موجوداتی هستند که فقط در زیر میکروسکوپ دیده می شوند. آن ها نقش مهمی در زمینه های مختلف مانند پزشکی ایفا می کنند. برای مطالعه این موجودات، دانشمندان روشی به نام کشت ابداع کرده اند که در آن میکروارگانیسم ها در یک محیط کنترل شده به نام محیط کشت رشد می کنند. اما محیط کشت دقیقا چیست و انتخاب محیط کشت مناسب براساس چه معیارهایی است؟
میکروارگانیسم های مختلف در شرایط مختلف رشد پیدا می کنند. شناسایی بهترین نوع کشت برای انواع مختلف میکروارگانیسم ها برای رشد و نمو بهتر آن ها ضروری است. با درک نیاز های خاص باکتری ها، قارچ ها، ویروس ها و تک یاخته ها، محققان و میکروبیولوژیست ها می توانند شرایط کشت بهینه را برای رشد این موجودات متنوع ایجاد کنند.
انواع محیط کشت ایبرسکو، باکیفیت ترین محیط کشت ایرانی موجود، در رویان ایران با بهترین قیمت به فروش می رسد.
انواع میکروارگانیسم ها و نیاز های کلی آن ها برای حیات
محیط کشت بستری است که مواد مغذی ضروری، رطوبت و محیطی مناسب برای رشد میکروارگانیسم ها را فراهم می کند. انواع مختلفی از محیط های کشت وجود دارد که هر کدام ترکیب و هدف خاص خود را دارند.
انواع ظروف کشت SPL اس پی ال کره را می توانید از رویان ایران، نمایندگی فروش محصولات اس پی ال SPL کره، خریداری کنید.
کشت باکتری
برای تعیین بهترین شرایط کشت برای یک باکتری خاص، عواملی مانند دما، سطح pH، در دسترس بودن مواد مغذی و اکسیژن مورد نیاز باید در نظر گرفته شوند. به عنوان مثال، باکتری های ترموفیل در محیط های با دمای بالا رشد می کنند و باکتری های اسیدوفیل سطوح pH پایین را ترجیح می دهند.
کشت قارچ
قارچ ها گروه دیگری از میکروارگانیسم ها هستند که برای رشد مطلوب به شرایط کشت خاصی نیاز دارند. عواملی مانند سطح رطوبت، دما، pH و در دسترس بودن مواد مغذی نقش مهمی در تعیین بهترین کشت برای یک قارچ خاص دارند. به عنوان مثال، کپک ها در محیط هایی با رطوبت بالا رشد می کنند، در حالی که مخمر ها شرایط تقریبا اسیدی را ترجیح می دهند.
کشت ویروس
ویروس ها برای تکثیر و رشد به یک سلول میزبان نیاز دارند. ایجاد بهترین شرایط کشت برای ویروس ها فراهم کردن سلول میزبان مناسب و محیط های مغذی برای تکثیر آن ها است. هر نوع ویروس ممکن است نیاز های خاصی برای رشد داشته باشد، که این امر ضروری است که شرایط کشت بر اساس آن تنظیم شود.
کشت تک سلولی
تک سلولی ها موجودات یوکاریوتی و یک سلول هستند که محیط کشت آن ها باید از نظر مواد مغذی، دما، pH و سطوح اکسیژن متناسب با نیاز آن ها فراهم شود. برخی از تک سلولی ها ممکن است به شرایط محیطی خاصی مانند محیط های بی هوازی یا هوازی برای رشد نیاز داشته باشند.
انتخاب محیط کشت مناسب براساس نوع میکروب و نیازهای آن
به صورت کلی محیط کشت براساس نوع بستر به سه دسته محیط کشت مایع (براث)، محیط کشت جامد (آگار) و محیط کشت نیمه جامد (برای مشاهده حرکت باکتری ها) طبقه بندی می شود. البته هر کدام از این سه دسته نیز انواعی دارند. انتخاب محیط کشت مناسب باید بر اساس نیاز میکروارگانیسم صورت گیرد. میکروارگانیسم های مختلف نیاز های تغذیه ای متنوعی دارند که انتخاب محیط رشد مناسب را ضروری می کند.

محیط کشت جامد برای رشد چه میکروارگانیسم هایی مناسب است؟
یکی از رایج ترین انواع محیط های کشت، محیط کشت جامد (آگار) است. آگار که از جلبک های دریایی قرمز به دست می آید، یک ماده ژلاتینی است که بستر جامدی را برای رشد میکروارگانیسم ها فراهم می کند و یک محیط ایده آل برای رشد باکتری است. محیط کشت نوترینت آگار اغلب حاوی پپتون (پروتئین هیدرولیز شده)، عصاره گوشت، مخمر و کلرید سدیم است.
محیط کشت مایع برای رشد چه میکروارگانیسم هایی مناسب است؟
محیط های کشت مایع معمولاً برای رشد قارچ ها و مخمر ها استفاده می شوند. محیط کشت مایع اغلب حاوی قند ها، اسید های آمینه، ویتامین ها و مواد معدنی است که شرایط بهینه را برای رشد این موجودات فراهم می کنند. ماهیت مایع این محیط کشت، امکان مخلوط کردن آسان را فراهم می کند. همچنین با استفاده از این نوع محیط کشت امکان هوادهی برای رشد میکروارگانیسم های هوازی وجود دارد.

برخی دیگر از انواع محیط های کشت
محیط کشت غنی شده
این محیط کشت حاوی مقدار زیادی مواد مغذی نظیر ویتامین و لیپید است. مانند محیط کشت blood agar.
محیط کشت انتخابی
نوعی محیط کشت است که در ترکیبات آن از رنگ یا معرف خاصی برای مهار رشد گروهی از باکتری ها استفاده می شود و شرایط را برای رشد گروه دیگری از باکتری ها فراهم می کند. به عنوان مثال در محیط کشت فنیل اتیل الکل آگار فقط به باکتری های گرم مثبت اجازه رشد داده می شود و از رشد دیگر میکروارگانیسم ها جلوگیری می شود.
محیط کشت افتراقی
این نوع محیط کشت حاوی ترکیباتی است که می توان به واسطه آن ترکیبات در بین انواع مختلف یک میکروارگانیسم تمایز ایجاد کرد. به عنوان مثال محیط کشت مک کانکی یک نوع محیط کشت انتخابی-افتراقی است و در این کشت باکتری های لاکتوز مثبت با کلنی های صورتی از باکتری های لاکتوز منفی با کلنی ها بی رنگ تمایز داده می شوند.
انتخاب محیط کشت مناسب بر اساس نیازهایی به غیر از عوامل تغذیه
به غیر از عوامل تغذیه ای، سایر شرایط محیطی نظیر دما، pH و در دسترس بودن اکسیژن فاکتور های مهمی هستند که نقش تعیین کننده ای در انتخاب محیط کشت مناسب دارند.
به عنوان مثال باکتری های گرمادوست (ترموفیل) دماهای بالاتر از 50 تا 80 درجه سانتی گراد را ترجیح می دهند، در حالی که باکتری های سرما دوست (سایکروفیل) در محیط های سردتر و زیر 20 درجه سانتی گراد رشد می کنند.
چه عوامل دیگری را هنگام انتخاب محیط کشت مناسب در نظر بگیریم؟
برند، کشور مبدا، آنالیزهای محصول، گواهی نامه ها و استانداردها و … همگی جز عوامل مهم هستند که هنگام انتخاب محیط کشت مناسب و خرید آن باید در نظر بگیرید. در حال حاضر برند مرک در ایران اغلب تقلبی بوده و نمی توانید اطمینانی به کیفیت محصول داشته باشید.

رویان ایران، انواع محیط کشت های ایبرسکو باکیفیت بالا و ارائه آنالیزهای محصول با بیش از 20 سال قدمت را برای آزمایشگاه های صنایع، پزشکی، دانشگاه ها و مراکز تحقیقاتی، پیشنهاد می کند.
خرید محیط کشت ایبرسکو و دیگر تجهیزات ضروری برای کشت میکروارگانیسم از رویان ایران
در این مقاله اطلاعات ضروری برای انتخاب محیط کشت را ارائه دهیم تا هنگام خرید دچار سردرگمی نشوید. یکی از بهترین برندهای محیط کشت آزمایشگاهی، ایبرسکو است. درحال حاضر اغلب برندهای خارجی محیط کشت در ایران تقلبی هستند. محیط کشت ایرانی ایبرسکو دارای گواهی نامه های استاندارد ملی و بین المللی همراه با آنالیز محصول به قیمت تولید کننده در رویان ایران عرضه می شوند. برای رشد و کشت انواع مختلف میکروارگانیسم به محیط کشت ایبرسکو، پلیت یا پتری دیش، ظروف آزمایشگاهی، انکوباتور و چراغ بونزن نیاز است. شما می توانید این تجهیزات را از رویان ایران مرجع فروش تجهیزات آزمایشگاهی ایران خریداری کنید.

